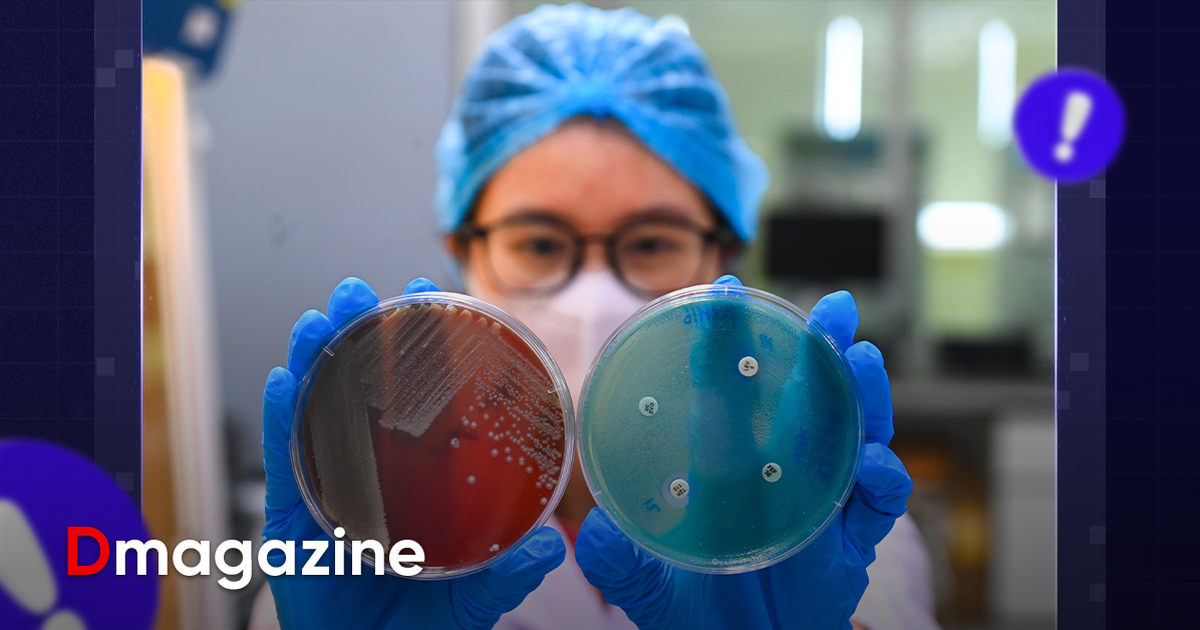

Vén màn nghề lạ của những “thợ săn vi khuẩn”
“Chuẩn bị máy, đồ bảo hộ, làm luôn”, BS Phạm Văn Phúc – Phó Giám đốc Trung tâm Hồi sức tích cực, Bệnh viện Bệnh Nhiệt đới Trung ương vừa dứt lời, cả ê-kíp đã tất bật di chuyển trong phòng bệnh hồi sức. Một ca nội soi phế quản khẩn cấp được triển khai…

